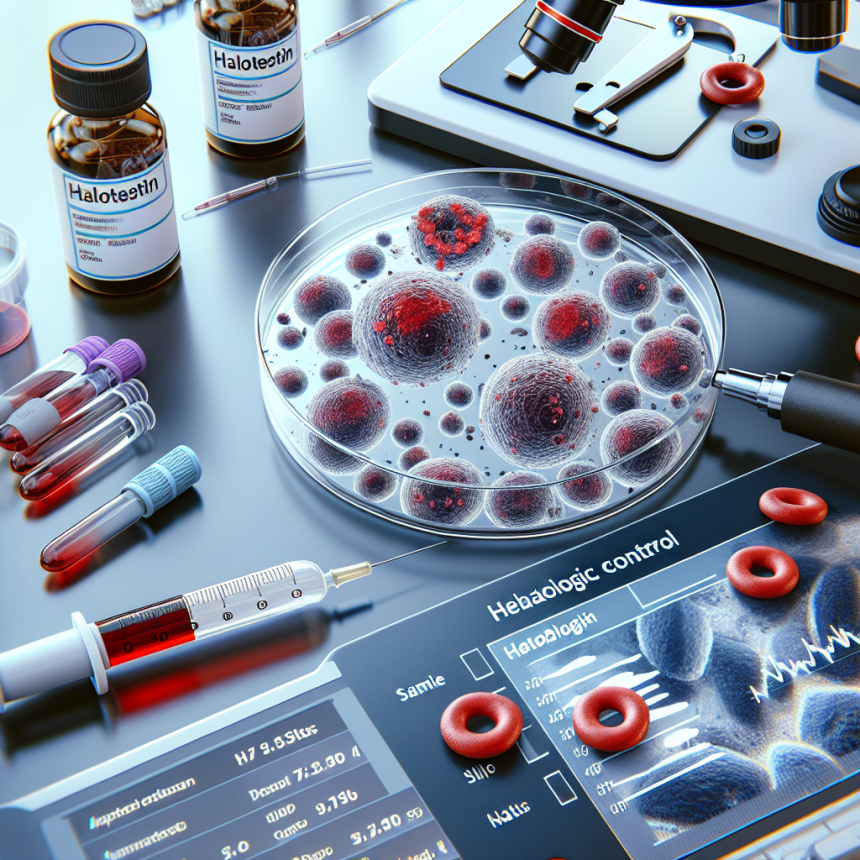
Halotestin et contrôle hématologique

-
Table of Contents
- Halotestin et contrôle hématologique : ce que les sportifs doivent savoir
- Qu’est-ce que le Halotestin et comment est-il utilisé dans le sport ?
- Quels sont les effets du Halotestin sur le contrôle hématologique ?
- Conseils et mises en garde pour les sportifs utilisant le Halotestin
- Consultez un médecin avant de commencer à utiliser le Halotestin
- Respectez la dose recommandée et la durée d’utilisation
- Surveillez régulièrement votre contrôle hématologique
- Avis d’experts dans le domaine de la pharmacologie sportive
Halotestin et contrôle hématologique : ce que les sportifs doivent savoir
Les sportifs de haut niveau sont constamment à la recherche de moyens pour améliorer leurs performances physiques et atteindre leurs objectifs. Cela peut inclure l’utilisation de médicaments et de compléments alimentaires pour augmenter leur force, leur endurance et leur masse musculaire. Cependant, il est important de comprendre les risques et les effets secondaires potentiels de ces substances sur la santé, en particulier en ce qui concerne le contrôle hématologique. Dans cet article, nous allons nous pencher sur l’un des médicaments les plus controversés dans le monde du sport : le Halotestin.
Qu’est-ce que le Halotestin et comment est-il utilisé dans le sport ?
Le Halotestin, également connu sous le nom de fluoxymestérone, est un stéroïde anabolisant synthétique dérivé de la testostérone. Il est principalement utilisé pour traiter les déficits en testostérone chez les hommes et les femmes, ainsi que pour traiter certains types de cancer du sein chez les femmes. Cependant, en raison de ses effets sur la force et la masse musculaire, il est également utilisé par les sportifs pour améliorer leurs performances.
Le Halotestin est généralement pris par voie orale et est rapidement absorbé par l’organisme. Il a une demi-vie relativement courte, ce qui signifie qu’il reste actif dans le corps pendant environ 9 heures. Cela peut nécessiter une prise quotidienne pour maintenir des niveaux stables dans le sang.
Quels sont les effets du Halotestin sur le contrôle hématologique ?
Le contrôle hématologique est un processus qui mesure les différents composants du sang, tels que les globules rouges, les globules blancs et les plaquettes. Ces composants sont essentiels pour la santé et la performance physique des sportifs. Cependant, l’utilisation de Halotestin peut entraîner des changements dans ces composants, ce qui peut avoir des conséquences néfastes sur la santé.
Le Halotestin peut augmenter le nombre de globules rouges dans le sang, ce qui peut améliorer l’oxygénation des muscles et augmenter l’endurance. Cependant, cela peut également augmenter le risque de caillots sanguins et de maladies cardiovasculaires. De plus, il peut également réduire le nombre de globules blancs, ce qui peut affaiblir le système immunitaire et augmenter le risque d’infections.
En ce qui concerne les plaquettes, le Halotestin peut les augmenter ou les diminuer en fonction de la dose et de la durée d’utilisation. Une augmentation des plaquettes peut augmenter le risque de caillots sanguins, tandis qu’une diminution peut entraîner des problèmes de coagulation et de saignement excessif.
Conseils et mises en garde pour les sportifs utilisant le Halotestin
Si vous envisagez d’utiliser le Halotestin pour améliorer vos performances sportives, il est important de prendre en compte les conseils et les mises en garde suivants :
Consultez un médecin avant de commencer à utiliser le Halotestin
Il est essentiel de consulter un médecin avant de prendre tout médicament ou complément alimentaire, en particulier ceux qui peuvent avoir un impact sur votre santé. Un médecin pourra évaluer votre état de santé et vous conseiller sur les risques et les effets secondaires potentiels du Halotestin.
Respectez la dose recommandée et la durée d’utilisation
Il est important de suivre les instructions du médecin ou du fabricant en ce qui concerne la dose et la durée d’utilisation du Halotestin. Une utilisation excessive ou prolongée peut entraîner des effets secondaires graves sur la santé.
Surveillez régulièrement votre contrôle hématologique
Si vous utilisez le Halotestin, il est recommandé de surveiller régulièrement votre contrôle hématologique pour détecter tout changement dans les composants sanguins. Si vous remarquez des anomalies, consultez immédiatement un médecin.
Avis d’experts dans le domaine de la pharmacologie sportive
Les experts dans le domaine de la pharmacologie sportive soulignent l’importance de comprendre les risques et les effets secondaires potentiels des médicaments et des compléments alimentaires utilisés pour améliorer les performances sportives. Ils recommandent également de consulter un médecin avant de prendre tout produit et de surveiller régulièrement le contrôle hématologique pour détecter tout changement dans les composants sanguins.
En conclusion, le Halotestin peut être un outil efficace pour améliorer les performances physiques, mais il est important de prendre en compte les risques et les effets secondaires potentiels sur la santé. Consultez toujours un médecin avant de prendre tout médicament ou complément alimentaire, et surveillez régulièrement votre contrôle hématologique pour détecter tout changement dans les composants sanguins. La santé doit toujours être la priorité numéro un pour les sportifs.